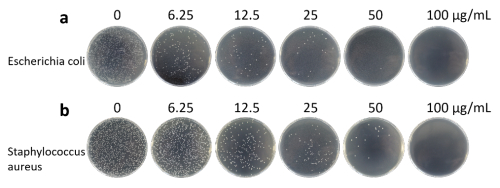

苏州医工所抑菌材料研究取得进展
中国科学院网站
健康医疗、化妆品和食品的细菌感染和细菌污染问题得到了越来越多的关注。随着检测手段的发展,消毒技术得到长足进步,但病原性细菌的精确测量和有效清除仍是当今科学家面临的挑战。为了克服这些障碍,科学家致力于设计和改善多功能平台来获得快速的细菌捕获效率并同时进行细菌检测和清除,多功能平台可能会极大促进临床诊断、环境检测和食品安全领域的发展。这些众多的尝试中,磁性纳米粒子凭借着自身优异的性质(可用于快速的细菌捕获、表面易于功能化进行细菌的靶向捕获以及优异的生物相容性等)被广泛用于检测和杀死细菌。然而,裸磁性纳米颗粒由于杀菌药物负载容量的限制以及较低的细菌捕获效率限制了其进一步的应用。因此,开发基于磁性的具有杰出细菌捕获、分离和清除性能于一体的纳米平台是亟须解决的难题。
中国科学院苏州生物医学工程技术研究所检验室研究员董文飞团队提供了一种具有各向异性的CTAB担载氨基修饰的磁介孔纳米粒子(Janus MSNs)的一步制备方法及其在抑菌材料中的应用,示意图见图1。该Janus MSNs表面带有正电荷,能够通过静电作用结合于带有负电荷的细菌表面,达到革兰阴性大肠杆菌和革兰氏阳性金黄色葡萄球菌的捕获和分离目的(图2),由于CTAB的杀菌性能从而有效消除革兰阴性大肠杆菌和革兰氏阳性金黄色葡萄球菌,该结果在细菌的LB-agar平板实验中得到验证(Janus MSNs对大肠杆菌和金黄色葡萄球菌的完全抑制浓度分别为50μg/ml和100μg/ml),平板的光学照片见图3。研究表明Janus MSN对革兰氏阳性菌和革兰氏阴性菌均具有优异的抑菌性能。
研究成果发表在RSC Advances上。

图1 CTAB担载氨基修饰的磁介孔纳米粒子(Janus MSNs)制备、捕获细菌及抑菌示意图

图2 (a)Janus MSNs电势图、Janus MSNs捕获(b)大肠杆菌和(c)金黄色葡萄球菌的SEM照片、外部磁场作用下Janus MSNs对大肠杆菌(d)和金黄色葡萄球菌(e)悬浮液(约107 CFU mL-1)抑菌和分离的光学照片。
图3 不同浓度CTAB担载氨基修饰的磁介孔纳米粒子分别对大肠杆菌(a)和金黄色葡萄球菌(b)的抗菌活性平板实验的光学照片。